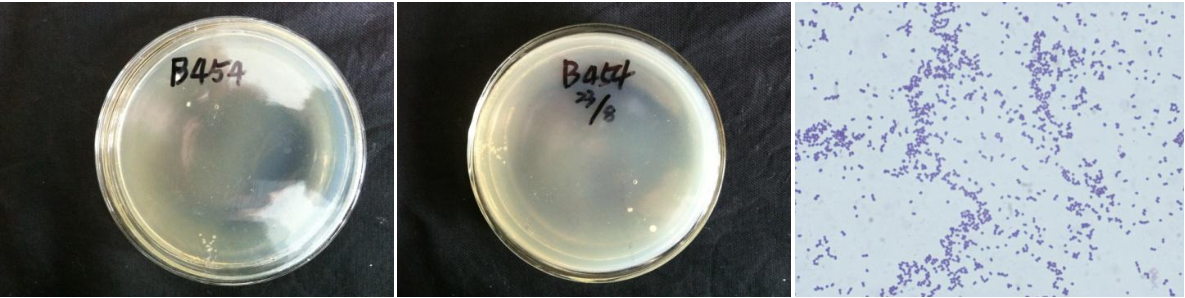

Loading...
| StrainNO | B454 |
| Classification | Enhydrobacter |
| 16s rDNA sequence | AACCCCCCCGTTGGGTAGCGCCCTCTTGCGTTAGGCTACCTACTTCGTGGTGCAATAGACTCCCATGGTGTGACGGGCGGTGTGT ACAAGGCCCGGGAACGTATTCACCGCAGCATTCTGATCTGCGATTACTAGCGATTCCGACTTCATGGAGTCGAGTTGCAGACTCC AATCCGGACTACGATAGGCTTTTTGAGATTAGCATCACATCGCTGTGTAGCAACCCTCTGTACCTACCATTGTAGCACGTGTGTA GCCCTGGTCGTAAGGGCCATGATGACTTGACGTCGTCCCCGCCTTCCTCCAGTTTGTCACTGGCAGTATCCTTAAAGTTCCCGGC TTAACCCGCTGGCAAATAAGGAAAAGGGTTGCGCTCGTTGCGGGACTTAACCCAACATCTCACGACACGAGCTGACGACAGCCAT GCAGCACCTGTATGTGAATTCCCGAAGGCACTCCCGCATCTCTGCAGGATTCTCACTATGTCAAGACCAGGTAAGGTTCTTCGCG TTGCATCGAATTAAACCACATGCTCCACCGCTTGTGCGGGCCCCCGTCAATTCATTTGAGTTTTAACCTTGCGGCCGTACTCCCC AGGCGGTCTACTTATCGCGTTAACTGCGCCACTAAAGTCTCAAGGACCCCAACGGCTAGTAGACATCGTTTACGGCGTGGACTAC CAGGGTATCTAATCCTGTTTGCTACCCACGCTTTCGAATCTCAGTGTCAATATTATGCCAGGAAGCTGCCTTCGCCATCGGTATT CCTCCAGATCTCTACGCATTTCACCGCTACACCTGGAATTCTACTTCCCTCTCACATATTCTAGCACCACCAGTATCACATGCAG TTCCCAGGTTAAGCCCGGGGATTTCACATGTGACTTAATGAGCCACCTACACTCGCTTTACGCCCAGTAATTCCGATTAACGCTC GCACCCTCTGTATTACCGCGGCTGCTGGCACAGAGTTAGCCGGTGCTTATTCTGCAGGTAACGTCTAATCTAATGGGTATTAACC ATTAGCCTCTCCTCCCTGCTTAAAGTGCTTTACAACCAAAAGGCCTTCTTCACACACGCGGCATGGCTGGATCAGGGTTGCCCCC ATTGTCCAATATTCCCCACTGCTGCCTCCCGTAGGAGTCCGGACCGTGTCTCAGTTCCGGTGTGACTGATCATCCTCTCAGACCA GTTACAGATCGTCGCCTTGGTGGGCCTTTACCCCACCAACTAGCTAATCTGATTTAGGCTCATCTAATAGCAAGAGCTTGCGCCC CCTTTCACCCGTAGGTCGTATGCGGTATTAATTCGAGTTTCCCCGAGCTATCCCCCACTACTAGGCAGATTCCTAAATGTTACTC ACCCGTCCGCCACTAATCATCTCCAGCAAGCTGGAGAATCATCGTGCGACTTGCATGGTAAGCCCCCCCCCAC |
| Strain Morphology Photos | |
| Morphological Description | Colony round;clam white;flat;edge neatly;slippy;sticky;translucent;Spherical shape of the bacterium;no spore |